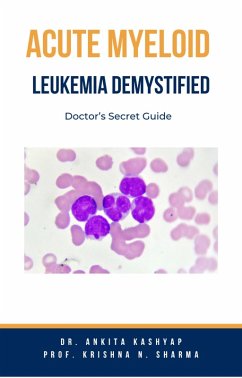

Acute Bronchitis Demystified: Doctor's Secret Guide (eBook, ePUB)

PAYBACK Punkte
0 °P sammeln!
"Acute Bronchitis Demystified: Doctor's Secret Guide" is your comprehensive resource for understanding and managing acute bronchitis. Dr. [Author's Name] takes you on a journey through the intricacies of this respiratory condition, starting with the basics-defining acute bronchitis and exploring its causes and triggers. Using the biopsychosocial model, the book delves into the anatomy of the respiratory system, debunking myths and providing facts about bronchitis. Treatment options, from medications and breathing exercises to the role of rest and recovery, are outlined, along with a focus on d...
"Acute Bronchitis Demystified: Doctor's Secret Guide" is your comprehensive resource for understanding and managing acute bronchitis. Dr. [Author's Name] takes you on a journey through the intricacies of this respiratory condition, starting with the basics-defining acute bronchitis and exploring its causes and triggers. Using the biopsychosocial model, the book delves into the anatomy of the respiratory system, debunking myths and providing facts about bronchitis. Treatment options, from medications and breathing exercises to the role of rest and recovery, are outlined, along with a focus on diet and nutrition for lung health. Alternative therapies and remedies, combined with stress management techniques, offer a holistic approach to prevention and recovery. Patient stories underscore resilience and recovery, shedding light on the psychological impact of acute bronchitis and coping mechanisms for stress. Lifestyle modifications, including hygiene, exercise, and environmental considerations, become essential components for prevention. The book navigates healthcare systems, helping you understand health insurance, choose the right healthcare provider, and decode medical jargon. Looking towards the future, it explores advancements in respiratory medicine, personalized treatments, breakthroughs in immunotherapy, and the role of AI in diagnosing respiratory diseases. "Acute Bronchitis Demystified" not only equips you with the knowledge to manage acute bronchitis effectively but also empowers you to embrace a proactive approach to respiratory health.
Dieser Download kann aus rechtlichen Gründen nur mit Rechnungsadresse in A, B, CY, CZ, D, DK, EW, E, FIN, F, GR, H, IRL, I, LT, L, LR, M, NL, PL, P, R, S, SLO, SK ausgeliefert werden.